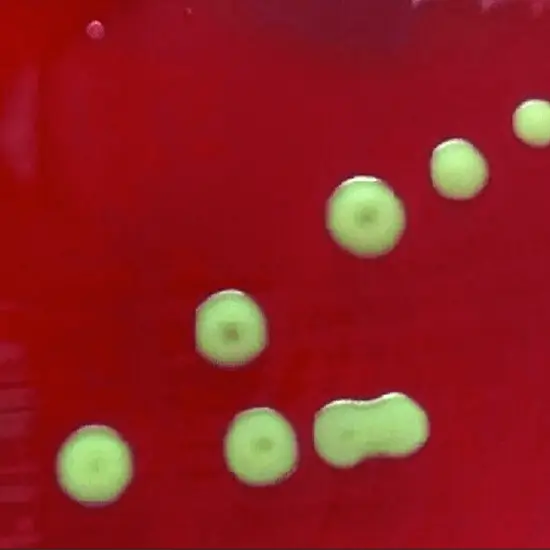

Book Aerobic Culture CSF Appointment Online Near me at the best price in Delhi/NCR from Ganesh Diagnostic. NABL & NABH Accredited Diagnostic centre and Pathology lab in Delhi offering a wide range of Radiology & Pathology tests. Get Free Ambulance & Free Home Sample collection. 24X7 Hour Open. Call Now at 011-47-444-444 to Book your Aerobic Culture CSF at 50% Discount.
CSF (Cerebrospinal fluid) is a clear fluid that protects both brain and spinal cord from injury.
A Culture Aerobic CSF (cerebrospinal fluid) is for identifying the possible pathogenic organisms such as bacteria, fungi, and viruses that progress in the space around the spinal cord. The culture aerobic CSF helps in deciding the best suitable antibiotic for the treatment of infection caused by pathogenic organisms.
The doctor asks for this culture aerobic CSF test for the mentioned reasons
2 ml to 5 ml Cerebrospinal Fluid Sample (CSF Fluid)
The doctor will guide you regarding the preparation for the spinal tap to collect the fluid sample
The negative result (normal result) clarifies that there is no growth of the pathogenic organism in the sample.
The positive result (an abnormal result) clarifies that pathogenic organisms are present in the sample. It may be due to meningitis which is an infection of the membranes which cover both the brain and spinal cord.
The average price for Aerobic Culture, CSF test is seen to differ from one center to another. The price range is said to be between INR 500 to INR 2300 in Delhi, India.
| Test Type | Aerobic Culture CSF |
| Includes | Culture Aerobic CSF Test (Neurology) |
| Preparation | |
| Reporting | Within 24 hours* |
| Test Price |
₹ 550
|

A laboratory test called a cerebrospinal fluid (CSF) culture is used to check for viruses, bacteria, and fungus in the fluid that surrounds the spinal cord. The CSF's function is to prevent damage to the brain and spinal cord.
Most, if not all, clinically relevant positive blood and CSF results with the current culture technique are reported within 48 hours of the culture being incubated.
For the purpose of isolating and identifying bacteria, the sediment of CSF samples was seeded onto blood agar, chocolate agar, and MacConkey agar plates. Additionally, cytological and chemical analyses were carried out in accordance with standard operating procedures.
PCGS and antibiotic agent selection in the case of bacterial meningitis. Gram-positive diplococci or cocci in chains indicated Streptococcus pneumoniae, Streptococcus spp., Enterococcus spp., or other Gram-positives, including Lactococcus, in the CSF stained with Gram stain.
Your CSF IgG index quantifies the amount of IgG present in your brain fluid. Normally, your cerebrospinal fluid contains very little IgG. Elevated IgG levels could indicate an inflammatory, autoimmune, or viral illness affecting your central nervous system.
The four most prevalent proteins that were found to be present at high concentrations in both the CSF and blood are albumin, cystatin C, serotransferrin, and transthyretin.
The sample needs to be forwarded to the department of pathology, microbiology, or biochemistry for storage. In two to three hours, it ought to be frozen. While a standard -20°C freezer would do, it is preferable if the lab has a -70°C or -80°C freezer.
You could get yourself tested for Aerobic CSF culture Test at Ganesh Diagnostic and Imaging Center. We would be happy to assist you in getting your sample by trained staff and technicians.
Yes, everybody is eligible for a FREE Home Sample Collection for Aerobic CSF culture Test from Ganesh Diagnostic and Imaging Center. Our trained phlebotomist would draw your sample from the convenience of your home. We also provide online support and would send your reports digitally on your phone through whatsapp as well.
Early check ups are always better than delayed ones. Safety, precaution & care is depicted from the several health checkups. Here, we present simple & comprehensive health packages for any kind of testing to ensure the early prescribed treatment to safeguard your health.